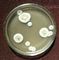

- Аспергиллёз
- (aspergillosis) — заболевание, вызываемое плесневыми грибками рода Aspergillus и характеризующееся поражением различных органов, чаще бронхолегочной системы; протекают, как правило, хронически с аллергическими и (или) токсическими проявлениями
Этиология, эпидемиология, патогенез. Чаще возбудителями аспергиллеза являются следующие виды аспергилл: Aspergillus fumigatus, Aspergillus flavus, Aspergillus niger и Aspergillus nidulans. Являются гетеротрофами, аэробами; растут при рН среды 3,0—8,0 и температуре до 50°. Культуры грибка длительно сохраняются при замораживании, высушивании. Рост аспергилл подавляют растворы гидрокарбоната натрия, перманганата калия.
Аспергиллы широко распространены во внешней среде. Им принадлежит ведущая роль в порче зерна, сена, обсеменении продуктов микробиологического синтеза кормового назначения, сырья для ткацких фабрик. Их часто обнаруживают в воздухе, в системах кондиционирования воздуха, соскобах со стен, потолков, пола бытовых и больничных учреждений, в смывах с медицинского инструментария, предметов обихода. Благоприятной средой для развития грибниц являются сырые стены, потолок, пол. В переносе грибков участвуют тараканы и другие насекомые.
Экзогенный аспергиллёз развивается при аэрогенном (вдыхание спор грибка), алиментарном (употребление зараженных грибками продуктов питания, например мяса больных аспергиллёзом кур) и контактном (через поврежденные кожу, слизистые оболочки) инфицировании. Контактное инфицирование наблюдается редко. Возможность заражения здорового человека от больного А. не установлена. Эндогенный аспергиллез возникает по типу аутоинфекции при активации аспергилл, обитающих на поверхности кожи и слизистых оболочек. Описан случай трансплацентарного инфицирования.
Развитию аспергиллёза способствуют снижение сопротивляемости организма, связанное с недостаточным питанием, предшествующим заболеванием (туберкулезом, анкилозирующим спондилитом, абсцессом легкого и др.), применением иммунодепрессантов, цитостатиков, лучевой терапии; дисбактериоз, обусловленный нерациональной антибиотикотерапией; длительное пребывание в запыленном и (или) сыром помещении с плохой вентиляцией. Нередко аспергиллез развивается как профессиональное заболевание у работающих на предприятиях, где применяют аспергиллы, продуцирующие ферменты (производство лимонной кислоты, этилового спирта, органических кислот); у лиц, соприкасающихся с обсемененным аспергиллами сырьем (работников пивоваренных, хлопкоочистительных заводов, ткацких фабрик, зернохранилищ и др.). Чаще аспергиллёз возникает вторично на фоне какого-либо заболевания (туберкулеза, эндокринопатий. опухоли, болезни крови, синдрома приобретенного иммунного дефицита и др.). У здорового человека аспергиллёз развивается лишь при внедрении массивных доз грибка (первичный А. ).
При благоприятных условиях аспергиллы внедряются в ткани, где, размножаясь, дают начало развитию микотического процесса. Чаще поражается бронхолегочная система (бронхолегочный аспергиллёз ), несколько реже — наружное ухо, слизистая оболочка носа, околоносовые пазухи, миндалины. К редким поражениям относят аспергиллёз кожи, глаз, ц.н.с., желудочно-киш. тракта, печени, селезенки, почек, поражение стопы (см. Мицетома стопы).
Патологический процесс может быть локализованным (например, аспергиллома легких) или распространенным (например, аспергиллезный трахеобронхит). Иногда наблюдается гематогенное распространение инфекции (метастатический аспергиллёз ), возможно развитие генерализованного А. Помимо непосредственного повреждения органов аспергиллы могут вызывать микотоксикозы — заболевания, обусловленные токсическими метаболитами грибков (например, афлотоксинами).
Споры грибка Aspergillus fumigatus в ассоциации со спорами грибков Micropolyspora faeni и Thermoactinomyces vulgaris могут быть причиной развития экзогенного аллергического альвеолита — «легкого фермера» (см. Альвеолиты). Участились смешанные инфекции, обусловленные грибками разных родов (например, Aspergillus и Candida, Aspergillus и Actinomyces), и сочетанные инфекции (например, вызванные аспергиллами и микобактерией туберкулеза).
Морфологические изменения при аспергиллёзе характеризуются некрозом тканей в месте внедрения грибка. Среди некротических масс выявляют элементы грибка. Возможно абсцедирование очага поражения. Вокруг зоны некроза при длительном течении патологического процесса развивается грануляционная ткань — гранулема. Мицелий грибка прорастает стенку кровеносных сосудов.
Клиническая картина определяется локализацией патологического процесса. Первичный экзогенный бронхолегочный аспергиллёз характеризуется развитием трахеобронхита, реже пневмонии. Инкубационный период при массивном аэрогенном инфицировании — 15—20 мин, при меньшей дозе ингалированного грибка — увеличивается до 3 сут. Вначале наблюдаются непреходящее чувство горечи во рту, першение в горле, сухой кашель. Затем возникают одышка, потливость, сердцебиение, головная боль, «ломота в теле», артралгии, озноб, фебрильная лихорадка; в легких могут выслушиваться сухие хрипы. В тяжелых случаях появляется мокрота, определяются влажные хрипы в легких. При рациональной терапии заболевание заканчивается выздоровлением через 7—10 дней. Иногда (например, при отсутствии лечения) процесс принимает хроническое течение, сходное с течением эндогенного бронхолегочного А. Вторичный экзогенный бронхолегочный аспергиллёз протекает так же, как эндогенный бронхолегочный А.
Эндогенный бронхолегочный аспергиллёз (первичный и вторичный) характеризуется развитием бронхопневмонии с астматическим синдромом. Различают начальный и хронический периоды болезни. Начальный период в большинстве случаев протекает менее остро, чем первичный экзогенный бронхолегочный А. Он проявляется болями в груди, приступообразным кашлем со слизисто-гнойной мокротой (при вторичном бронхолегочном аспергиллёзе , развившемся на фоне заболевания легких, отмечается усиление кашля), кровохарканьем, признаками бронхоспазма, плесневым запахом изо рта, потливостью в ночное время, недомоганием, субфебрилитетом, потерей массы тела. Над областью поражения определяют ослабленное дыхание, хрипы (вначале сухие, затем влажные); если очаг поражения расположен субплеврально, над ним выявляют притупление перкуторного звука. У больных с опухолью или туберкулезом дыхательных путей эндогенный бронхолегочный А. может начаться внезапно, в этих случаях заболевание протекает более тяжело.
Хронический период характеризуется сменой фаз обострения и ремиссии, что обусловлено, в частности, чередованием фаз размножения грибка и угнетения его роста. В фазе обострения отмечаются недомогание, кашель (сухой или с мокротой), кровохарканье, одышка в покое, цианоз, ознобы, эозинофилия, лейкоцитоз, повышение СОЭ, протеинурия, большое количество эозинофилов в мокроте. Возможно абсцедирование очага с прорывом абсцесса в плевральную полость или в дренирующий бронх, что ведет к диссеминации грибков. В фазе обострения могут возникать кратковременные обильные легочные кровотечения, приступы удушья по типу бронхиальной астмы. Физикально в зоне поражения определяют ослабленное дыхание, влажные и сухие хрипы, притупление перкуторного звука.
При прогрессировании процесса болезнь переходит в деструктивную, необратимую стадию развития. Нарастают пневмофиброз, формируются бронхоэктазы, в которых создается благоприятная среда для развития аспергилл. При рентгенологическом исследовании легких обнаруживают диссеминированные милиарные и мелкоочаговые затенения, отдельные крупные плотные затенения инфильтративного характера без четких контуров. В области крупных затенений выявляют признаки некроза, абсцедирования, могут появляться полости с уровнем жидкости. Наряду с этим возможны нестойкие (быстро исчезающие) затенения — эозинофильные инфильтраты; ателектаз легкого. Нередко определяются мелко- или крупноячеистая деформация легочного рисунка, тяжистые и параллельные линейные тени (бронхит, перибронхит), признаки компенсаторной эмфиземы и фиброза легких. Корень пораженного легкого расширен. При длительном течении формируются фиброзно-кистозные изменения легочной ткани. Бронхоскопически в фазе обострения выявляют отек слизистой оболочки бронха, сужение его просвета или обтурацию бронха слизистой пробкой.
В фазе ремиссии признаки заболевания менее выражены. Переход к фазе ремиссии при отсутствии лечения характеризуется откашливанием крошковидного или пушистого комочка или слизистой пробки желтовато-зеленоватого, зеленовато-коричневого цвета с запахом плесени. Постепенное снижение степени тяжести обострений укрывает на тенденцию патологического процесса к регрессированию.
Аспергиллома легких представляет собой локализованную форму бронхолегочного аспергиллеза , при которой в легких обнаруживают полость, содержащую колонии грибков и сообщающуюся с просветом бронхов. Как правило, аспергиллома возникает в результате инфицирования грибками предсуществующей в легких полости (например, после излечения кавернозного туберкулеза или абсцесса легкого). Множественные аспергилломы могут образовываться при бронхоэктазах (в расширенных и деформированных бронхах), иногда (например, при болезнях крови) они формируются без предшествующей деструкции бронхов и легочной ткани. Часто аспергиллома протекает бессимптомно и выявляется случайно (например, при флюорографии). Возможны острое начало заболевания с ознобом, повышением температуры тела, потливостью, приступообразным кашлем, обильной мокротой, кровохарканьем. Осложнением аспергилломы легких может быть массивное легочное кровотечение. Рентгенографически в легких выявляют полость (реже две полости и более) диаметром 2—5 см, иногда до 10—15 см; внутри полости имеется округлое затенение, между ним и стенкой полости определяется серпообразный венчик просветления (рис. 1), который может смещаться при изменении положения тела больного. Между корнем легкого и аспергилломой может обнаруживаться «дорожка» (дренирующий бронх с уплотненными стенками), лучше она видна на томограммах (рис. 2). При бронхоскопии обнаруживают катаральное воспаление слизистой оболочки и деформацию бронхов: если бронхоскоп попадает в аспергиллому, выявляется белый, серый, желтый или зеленоватый налет, плотно сращенный со стенками полости.
Аспергиллез уха, слизистой оболочки носа, околоносовых пазух и миндалин возникает чаще на фоне неспецифического воспалительного или атрофического процесса, после операций, травм. Аспергиллёз уха обычно проявляется поражением кожи наружного слухового прохода. При этом отмечаются гиперемия, инфильтрация, повышенная чувствительность кожи, образуются корочки, появляется отделяемое сероватого, желтого или черного цвета, без запаха. Больные жалуются на зуд в области наружного слухового прохода, чувство заложенности в ухе, иногда снижается слух, возникают головные боли. В редких случаях возможно поражение среднего и внутреннего уха.
Аспергиллез слизистой оболочки носа в начальном периоде и в фазе обострения хронического процесса протекает по типу вазомоторного ринита, одновременно наблюдается отделение темно-серых или коричневатых корок и пленок с неприятным запахом. Риноскопически определяют отечность слизистой оболочки, преимущественно в области средней и нижней носовых раковин. В хроническом периоде выявляют гиперплазию слизистой оболочки носа, полипы, инфильтративно-опухолевые образования, кровоточащие грануляции, возможна перфорация перегородки носа. Аспергиллез околоносовых пазух (аспергиллезный гайморит, этмоидит) сопровождается постоянной, резко выраженной, обычно односторонней заложенностью носа, мучительными головными болями. У детей раннего возраста аспергиллезные поражения чаще протекают по типу гнойного риносинусита, этмоидита.
Аспергиллезный тонзиллит, как правило, возникает на фоне неспецифического хронического тонзиллита или при травме миндалин (например, рыбьей костью) и характеризуется сильными болями в глотке, иррадиирующими в ухо. Поражение миндалин одностороннее, налеты желтовато-белого, сероватого или коричневатого цвета, переходят на небно-язычные дужки, под налетами определяется эрозированная поверхность. Возможны метастазирование инфекции и поражение других органов.
Аспергиллез других локализаций наблюдается редко. Аспергиллёз кожи, как правило, является первичным; проявляется эритемой, инфильтрацией, коричневатыми чешуйками, реже — везикулезными и папулезными элементами, интертриго, паронихиями, экзематозными, дисгидрозиформными, инфильтративно-язвенными, вегетирующими, располагающимися асимметрично элементами, иногда опоясанными коричневатой или зеленоватой каемкой. Зуд выражен умеренно. При аспергиллёзе кожи головы и шеи в процесс могут вовлекаться регионарные лимфатические узлы. Аспергиллы могут поражать ногти (онихомикоз), в этом случае ногтевые пластинки утолщаются, крошатся (зернистая или паклеобразная масса), приобретают темно-желтый, зеленоватый или коричневатый оттенок.
Аспергиллез ц.н.с. чаще развивается как метастатический процесс, протекает в виде менингита, энцефалита, менингоэнцефалита, абсцесса головного мозга.
Аспергиллез глаз в большинстве случаев является следствием гематогенного распространения инфекции; проявляется конъюнктивитом, язвенным блефаритом, дакриоциститом, кератитом (поверхностным узелковым или глубоким инфильтративно-язвенным): возможно развитие панофтальмита. При аспергиллезе глаз нередко наблюдается тромбоз сосудов. В случае вовлечения в процесс орбиты отмечаются отек в области глазницы, экзофтальм, птоз, поражение черепных нервов.
Аспергиллез желудочно-кишечного тракта развивается при дисбактериозе, протекает по типу эрозивного гастрита, энтерита или колита. А. печени характеризуется очаговым поражением; диффузный процесс может возникать при афлотоксикозе, в случае хронического течения ведет к развитию цирроза печени, может способствовать возникновению рака печени.
Диагноз основывается на клинико-эпидемиологических данных, результатах рентгенологического, инструментального и иммунологических методов исследований, микроскопического и культурального исследования патологического материала (мокроты, промывных вод бронхов, соскобов с поверхности пораженной кожи и др.), биопсии патологически измененных тканей.
При микроскопическом исследовании мазков, приготовленных из патологического материала, выявляют короткие веточки мономорфного, септированного, тонкого мицелия и одиночные или сгруппированные, округлые, шероховатые, бесцветные или пигментированные конидии (зрелые наружные споры) на конидиеносцах. Аспергиллы хорошо окрашиваются гематоксилин-эозином, хуже при PAS-реакции. При культуральном исследовании на питательной среде вырастают «пушистые» колонии, цвет которых зависит от вида грибка (рис. 3). Необходим постоянный контроль за содержанием грибков в воздухе лаборатории, т. к. положительные результаты микологического исследования могут быть вызваны ошибками в лабораторной технологии и нарушением правил хранения культур грибка. Диагностически информативными признаками аспергиллёза являются повторное обнаружение элементов грибков в патологическом материале, рост не менее 5 колоний в 1 мл среды, особенно при нарастании их числа в динамике и в сочетании с положительными серологическими реакциями. При бронхолегочном А. наиболее достоверно исследование бронхиальных смывов и материала, полученного при биопсии во время бронхоскопии.
При гистологическом исследовании (рис. 4) пораженной ткани грибки выявляются в виде клубка, в случае широкого доступа воздуха в ткани образуются характерные «леечные» головки грибка с цепочками конидий. С помощью серологической реакции по Оухтерлоню определяют антитела к аспергиллезному антигену. Диагностическое значение имеет также резко повышенный уровень иммуноглобулина Е в крови больных. В ряде случаев для уточнения диагноза применяют аллергические диагностические пробы, в т.ч. кожные и ингаляционные.
Дифференциальная диагностика сложна из-за сходства аспергиллёза со многими болезнями грибковой и негрибковой природы. В начальном периоде бронхолегочный аспергиллёз напоминает острые респираторные вирусные болезни, бронхит и пневмонию бактериальной или вирусной этиологии. В хроническом периоде он может иметь сходство с туберкулезом легких, пневмоцистозом, саркоидозом. муковисцидозом, кандидозом легких, опухолью легких и другими заболеваниями. Неэффективность антибактериальной, десенсибилизирующей, гормональной терапии указывает на возможность бронхолегочного аспергиллеза . Хронический бронхолегочный аспергиллёз можно заподозрить также при наличии астматического синдрома в сочетании с лихорадкой, увеличением количества мокроты во время обострения бронхолегочного процесса, повышенным содержанием эозинофилов в крови и мокроте, в сочетании с характерными рентгенологическими изменениями: нестойкими затенениями в легких, линейными параллельными тенями и др. Аспергиллёз кожи следует дифференцировать со споротрихозом, себорейной эритродермией; аспергиллёз ногтей напоминает онихоз при рубромикозе, эпидермофитии, поражение ногтей, вызванное синегнойной палочкой. Распространенный аспергиллёз с вовлечением слизистой оболочки носа и кожи лица может иметь сходство с сифилисом, туберкулезом, раком. В хроническом периоде аспергиллезного гайморита иногда ошибочно диагностируют мигрень. А. глаза и орбиты следует дифференцировать с актиномикозом, опухолями (меланомой и др.).
Лечение может проводиться в амбулаторных условиях врачом соответствующей специальности (в зависимости от локализации поражения) или в стационаре (пульмонологическом, оториноларингологическом, дерматологическом и др.). Показаниями для госпитализации являются тяжелое состояние больного, некупирующийся приступ бронхиальной астмы, кровохарканье, тенденция к прогрессированию патологического процесса. Назначают противогрибковые средства: амфотерицин В, амфоглюкамин, низорал, леворин, нистатин, декамин. Для подавления ассоциированной бактериальной флоры используют сульфаниламидные препараты, антибиотики короткими курсами. При бронхолегочном аспергиллёзе целесообразно ингаляционное введение амфотерицина В; на каждую ингаляцию — 25000 ЕД препарата, на курс 20 ингаляций (2 раза в день), повторный курс через 7—10 дней. В тяжелых случаях в начале курса лечения применяют внутривенные вливания амфотерицина В. При отсутствии противогрибковых средств или в сочетании с ними используют 10% раствор йодида натрия внутривенно, 20% раствор йодида калия внутрь, ингаляции эвкалиптового масла (15—20 капель масла на стакан воды). В фазе обострения хронического бронхолегочного аспергиллёза показаны короткие курсы преднизолона в начальной суточной дозе 30—40 мг с последующим снижением, дезинтоксикационная терапия. В фазе ремиссии рекомендуется стимулирующая, иммунокорригирующая терапия. При аспергилломе легких необходима радикальная операция (иссечение аспергилломы в пределах здоровых тканей) с обязательным назначением противогрибковых средств до и после операции. При аспергиллезе кожи, глаз, слизистой оболочки носа, миндалин важную роль играет местное лечение противогрибковыми средствами в сочетании с антисептиками и ферментами (химопсин и др.). Ориентирами эффективности лечения служат улучшение состояния больного и отрицательные результаты микологического исследования.
Больные аспергиллёзом подлежат диспансерному наблюдению. В связи с возможностью рецидива болезни наблюдение должно продолжаться после исчезновения ее проявлений в течение 1—2 лет при аспергиллёзе кожи, наружного уха, слизистой оболочки носа, околоносовых пазух и миндалин, в течение 2—3 лет при А. внутренних органов.
Прогноз при первичном экзогенном бронхолегочном аспергиллёзе благоприятный, при вторичном — во многом зависит от течения основного заболевания. У большинства лиц, перенесших легкую форму первичного экзогенного бронхолегочного аспергиллёза , здоровье восстанавливается полностью, лишь у части больных могут наблюдаться подверженность острым респираторным вирусным заболеваниям, повышенная чувствительность к аспергиллам. Хронический бронхолегочный аспергиллёз излечивается как инфекционный процесс, но стойкие остаточные изменения бронхов и легочной ткани могут обусловить профессиональные ограничения, инвалидность больного. Больные аспергиллёзом кожи, наружного уха, слизистой оболочки носа, околоносовых пазух, миндалин при своевременном адекватном лечении, как правило, выздоравливают. При аспергиллезе ц.н.с., глаз, печени, длительно нераспознанном аспергиллезе желудочно-кишечного тракта прогноз неблагоприятен.
Профилактика включает герметизацию технологических процессов, связанных с применением грибков, продуцирующих ферменты, и сырья, обсемененного грибками; использование респираторов при работе в условиях повышенной запыленности; микологический контроль окружающей среды; регулярные микологические обследования лиц из групп риска (соприкасающихся со спорами грибков в производственных условиях, получающих цитостатическую и длительную гормональную терапию, страдающих хроническими неспецифическими заболеваниями легких и др.).
Лабораторную посуду, медицинский инструментарий, инфицированные аспергиллами, дезинфицируют 5% растворами фенола, лизола, хлорамина, 10% раствором формальдегида, 0,1% раствором сулемы, синтетическими моющими средствами. Инфицированный грибками материал автоклавируют при 120 в течение 30 мин или кипятят в течение 15—20 мин.
См. также Грибки паразитические, Микозы.
Библиогр.: Дайняк Л.Б. и Кунельская В.Я. Микозы верхних дыхательных путей. М., 1979; Калинкин П.Н. и Шеклаков Н.Д. Руководство по медицинской микологии, с. 238, М., 1978; Лещенко В. М. Аспергиллез, М., 1973; Паразитоценология, под ред. А. П. Марковича, с. 168, Киев, 1985.